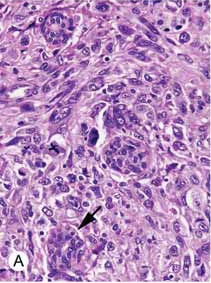
Invasive Ductal Carcinoma

Breast
The breast is essentially a modified sweat gland embryologically derived from the skin.
The milk line, which extends from the axilla to the vulva, is a region along which breast tissue can form anywhere.
The functional component of the breast is the terminal duct lobular unit (TLDU).
The terminal duct lobular unit consists of:
- Lobules that produce milk
- Ducts that allow milk to drain to the nipples
The luminal cell layer and the myoepithelial cell layer are the two layers of epithelium that line lobules and ducts.
The inner layer of cells that lines the ducts and lobules is called the luminal cell layer.
The luminal cell layer within the lobules is responsible for milk production.
Myoepithelial cell layer, on the other hand, is the outer cell layer lining ducts and lobules.
Contractile function propels milk towards the nipple knowing the fact that breast tissue is hormone sensitive.
Male and female breast tissue before puberty mostly consists of large ducts under the nipple.
After menarche, estrogen and progesterone are principally responsible for development, with lobule formation and tiny duct density being highest in the upper outer quadrant.
Especially before menstruation, breast tenderness during the menstrual cycle is a common complaint.
Breast lobules go through hyperplasia, which is a growth in cell count in an organ or tissue, most often experienced during pregnancy.
Estrogen and progesterone produced by the corpus are what cause hyperplasia.
Luteum (early first trimester), fetus, and placenta (later in pregnancy) after menopause, breast tissue undergoes atrophy.
Galactorrhea is the term for milk production that happens outside of lactation.
Causes of galactorrhea include:
- Drugs
- Nipple stimulation
- Prolactinoma of the anterior pituitary
Inflammatory Breast Conditions
Acute Mastitis
Acute mastitis is a rapid inflammation of the breast.
Acute mastitis is often due to a bacterial infection.
Staphylococcus aureus is a common cause of acute mastitis.
Acute mastitis is related to breastfeeding, and the nipple develops fissures that give microbes a way in.
Symptoms of acute mastitis include:
- A purulent nipple discharge
- Erythematous breast
- Abscess formation
Acute mastitis is treated with antibiotics.
Drainage may be necessary if an abscess has formed.
Periductal Mastitis
Periductal mastitis is subareolar duct inflammation.
Squamous metaplasia of lactiferous ducts is caused by a relative vitamin A deficiency, which causes duct blockage and inflammation.
Periductal mastitis is commonly detected in smokers.
Clinical signs of periductal mastitis include:
- Subareolar mass
- Retracted nipples
Mammary Duct Ectasia
Mammary duct ectasia is a rare condition where there is inflammation with dilation (ectasia) of the subareolar ducts.
Mammary duct ectasia typically occurs in postmenopausal women who are multiparous.
Mammary duct ectasia presents as a periareolar mass with green-brown nipple discharge (inflammatory debris).
Histology of mammary duct ectasia reveals chronic inflammation with plasma cells.
Fat Necrosis
Fat necrosis is a benign (non-cancerous) disorder called fat necrosis most frequently appears after trauma or injury to the breast tissue.
Although a history of trauma may not always be obvious, this disorder is typically linked to trauma.
Fat necrosis manifests as a mass during a physical examination or calcification during a mammogram due to saponification.
Histology of fat necrosis shows necrotic fat with accompanying calcifications and enormous cells.
Fibrocystic Changes
Fibrocystic changes are the development of fibrosis and cysts in the breast.
The most common change in the premenopausal breast is fibrocystic change, which is assumed to be hormone mediated.
Fibrocystic change may manifest as a vague irregular lump.
Both breasts are affected by benign changes, however some fibrocystic-related changes are linked to an elevated risk for invasive cancer.
No increased risks are shown by fibrosis, cysts, or apocrine metaplasia.
Sclerosing adenosis and ductal hyperplasia both indicate greater risk of progression to malignancy.
Intraductal Papilloma
Intraductal papillomas are wart-like tumors that grow within the milk ducts of the breast.
Intraductal papillomas are benign.
Intraductal papillomas are distinguished by the presence of fibrovascular projections lined by epithelial (luminal) and myoepithelial cells.
In a premenopausal woman, intraductal papillomas typically manifest as bloody nipple discharge.
Intraductal papillomas must be distinguished from papillary carcinoma, which represents bloody nipple discharge.
On histology, papillary carcinoma has fibrovascular projections lined by epithelial cells but lacking underlying myoepithelial cells.
The risk of papillary carcinoma increases with age.
Fibroadenoma
A fibroadenoma is a solid breast mass made up of fibrous tissue and glands.
Fibroadenomas are benign.
Fibroadenomas are the most common benign breast tumor.
Fibroadenomas commonly effect young women.
Fibroadenomas presents as a well-circumscribed, mobile marble-like mass
Additionally, fibroadenomas are estrogen-sensitive, which causes them to grow during pregnancy, and be uncomfortable in certain phases of the menstrual cycle.
Phyllodes Tumor
Phyllodes tumor is a tumor with an overgrowth of the fibrous component that resembles a fibroadenoma.
The histology of Phyllodes tumor shows leaf-like projections.
Phyllodes tumor is most frequently observed in postmenopausal women and.
In some very rare instances, Phyllodes tumor may become malignant.
Breast Cancer
Breast cancer is the most common variety of carcinoma in women, excluding skin cancer.
Breast cancer is the second most common cause of cancer mortality in women.
Risk factors for breast cancer include:
- BRCA mutations
- Family history of breast cancer
- Increased estrogen exposure
- Early menarche
- Late menopause
- Obesity
Types of breast tumors include:
- Ductal carcinoma in situ (DCIS)
- Invasive ductal carcinoma (IDC)
- Lobular carcinoma in situ (LCIS)
- Invasive lobular carcinoma (ILC)
Ductal Carcinoma In Situ (DCIS)
Ductal carcinoma in situ (DCIS) is the term for malignant ductal cell growth that does not involve basement membrane invasion.
Although ductal carcinoma in situ (DCIS) often shows up as calcification on mammography, it rarely results in a malignancy.
Mammographic calcifications can also be associated with benign disorders such as fat necrosis, sclerosing adenosis, and fibrocystic changes.
Biopsy of calcifications is often necessary to distinguish between benign and malignant conditions.
The comedo type of ductal carcinoma in situ (DCIS) is distinguished by high-grade cells with necrosis and dystrophic calcification in the core of ducts, whereas histologic subgroups of DCIS are based on architecture.
Ductal carcinoma in situ (DCIS) that spreads up the ducts to affect the skin of the nipple is called the Paget disease of the breast.
Paget disease of the breast presents as nipple ulceration and erythema.
There is nearly always an underlying carcinoma present when Paget disease of the breast develops.
Invasive Ductal Carcinoma (IDC)
Invasive ductal carcinoma (IDC) develops when duct lining cells transform and spread into surrounding breast tissue.
Invasive ductal carcinoma (IDC) is the most common type of breast cancer.
Invasive ductal carcinoma (IDC) may by detected by physical examination or mammography.
Mammographically identified masses are often 1.0 cm or greater, while masses found by physical exam are typically 2.0 cm or greater.
Skin dimpling or nipple retraction are possible side effects of advanced invasive ductal carcinoma (IDC).
Histology of invasive ductal carcinoma shows haphazard ductal cells in a desmoplastic stroma.
The prognosis of invasive ductal carcinoma (IDC) is good if caught and treated early.
Other types of breast cancers to have some familiarity with include:
- Tubular carcinoma
- Mucinous carcinoma
- Medullary carcinoma
- Inflammatory carcinoma
Tubular carcinoma is like invasive ductal carcinoma (IDC), but has slightly more tapered and pointed ended glands.
The lack of myoepithelial cells in well-differentiated tubules is a characteristic of tubular cancer.
Mucinous carcinoma is characterized by carcinoma with abundant extracellular mucin where tumor cells are floating in a mucus pool.
Medullary carcinoma shows large, high-grade cells developing in sheets and accompanied by lymphocytes and plasma cells.
Inflammatory carcinoma manifests as swollen, inflamed breast tissue with no apparent lump due to tumor cells blocking lymphatic drainage.
Lobular Carcinoma In Situ (LCIS)
Lobular carcinoma in situ (LCIS) consists of lobules with malignant cell growth but no invasion of the basement membrane.
Lobular carcinoma in situ (LCIS) is normally discovered by accident during a biopsy because it does not result in a mass or calcifications.
Histology of lobular carcinoma in situ (LCIS) is characterized by discohesive cells lacking E-cadherin adhesion protein and is often multifocal and bilateral.
Tamoxifen is used as treatment to lower the chance of developing subsequent carcinoid and, in addition, a close follow-up low risk of progression to invasive carcinoma.
Invasive Lobular Carcinoma (ILC)
An invasive carcinoma that typically develops in a single-file manner and may have cells with signet-ring morphology is referred to as invasive lobular carcinoma (ILC).
No duct formation is found at areas involved by invasive lobular carcinoma (ILC) due to lack of E-cadherin.
Prognostic Factors of Breast Cancer
The TNM staging system, which stands for tumor (T), nodes (N), and metastases (M), determines the prognosis for breast cancer.
Although metastasis is the most crucial element, most patients show up before metastasis happens.
Given that metastasis is uncommon at presentation, spread to axillary lymph nodes is the most helpful prognostic marker.
With sentinel lymph node biopsy, axillary lymph nodes can be assessed for malignant cells.
The most important factors that help determine treatment and prognosis for breast cancer include:
- Estrogen receptor (ER) status
- Progesterone receptor (PR) status
- HER2/neu gene amplification (overexpression) status
Both estrogen receptor (ER) and progesterone receptor (PR) are found in the nucleus, and their existence is linked to a response to anti-estrogenic drugs like tamoxifen.
Response to trastuzumab (aka Herceptin), a synthetic antibody targeting the HER2 receptor, is linked to HER2/neu amplification.
On the cell surface, there is a growth factor receptor called HER2/neu.
The prognosis is poor for “triple-negative” cancers, which are for ER, PR, and HER2/neu negative.
Triple-negative carcinoma is more likely to develop in African American women.
Hereditary Breast Cancer
Hereditary breast cancer accounts for 10% of all cases of breast cancer.
Several first-degree relatives with breast cancer, a tumor at an early age during premenopausal, and multiple tumors in a single patient are clinical characteristics that suggest hereditary breast cancer.
The most significant single gene mutations linked to hereditary breast cancer are BRCA1 and BRCA2.
Breast and ovarian cancer are both linked to BRCA1 mutations, whereas BRCA2 mutation is linked to male breast cancer as well.
Bilateral mastectomy, which involves removing both breasts, is an option for women who have a genetic predisposition to breast cancer in order to reduce their risk of getting carcinoma.
Some patients opt for prophylactic hysterectomy as well.
Male Breast Cancer
Male breast cancer patients make up just 1% of the total breast cancer population.
Male breast cancer usually presents as a subareolar mass in older males.
Males have the highest density of breast tissue beneath the nipple, which has the potential to produce a discharge.
Invasive ductal carcinoma (IDC) is the most prevalent subtype of breast cancer.
Lobular carcinoma is rare in males because the male breast develops very few lobules.
Risk factors for male breast cancer include:
- BRCA2 mutations
- Klinefelter syndrome (in which males have an extra X chromosome)